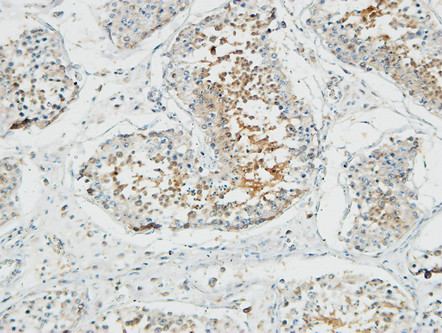

-
分类: 科研抗体货号: P23172别名: STEAP2; PCANAP1; STAMP1; Metalloreductase STEAP2; Prostate cancer-associated protein 1; Protein up-regulated in metastatic prostate cancer; PUMPCn; Six-transmembrane epithelial antigen of prostate 2; SixTransMembrane protein of prostate 1应用: IHC,IF反应种属: Human,Mouse
-
分类: 科研抗体货号: P23189别名: Probable D-lactate dehydrogenase; mitochondrial; DLD; Lactate dehydrogenase D应用: WB反应种属: Human,Mouse,Rat
-
分类: 科研抗体货号: P23171别名: PTCH1; PTCH; Protein patched homolog 1; PTC; PTC1应用: WB,IHC反应种属: Human,Mouse
-
分类: 科研抗体货号: P23188别名: Zinc finger protein 499; Zinc finger and BTB domain-containing protein 45; ZBTB45应用: WB,IHC反应种属: Human,Mouse,Rat
-
分类: 科研抗体货号: P23170别名: H1.8; H1oo; osH1应用: IHC,IF反应种属: Human
-
分类: 科研抗体货号: P23185别名: Alliin lyase 1应用: WB反应种属: Plant
-
分类: 科研抗体货号: P23195别名: Toll-Like Receptor 13; Toll like receptor 13 antibody应用: IHC反应种属: Human,Mouse,Rat
-
分类: 科研抗体货号: P23184别名: NT5C3; P5N1; UMPH1; HSPC233; Cytosolic 5'-nucleotidase 3; Cytosolic 5'-nucleotidase III; cN-III; Pyrimidine 5'-nucleotidase 1; P5'N-1; P5N-1; PN-I; Uridine 5'-monophosphate hydrolase 1; p36应用: WB反应种属: Human,Mouse
-
分类: 科研抗体货号: P23194别名: TLR4; Toll-like receptor 4; hToll; CD antigen CD284应用: IHC反应种属: Human,Mouse,Rat
-
分类: 科研抗体货号: P23183别名: MTNR1A; Melatonin receptor type 1A; Mel-1A-R; Mel1a receptor应用: IF反应种属: Human,Mouse,Rat

鄂公网安备42018502007531号
鄂公网安备42018502007531号

